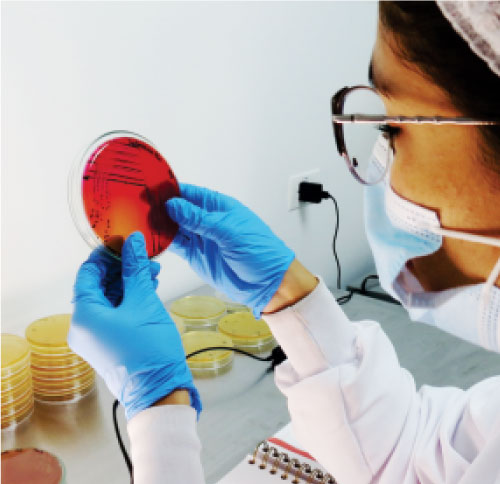

¿Qué está sucediendo?
Los antibióticos se descubrieron en 1928, y desde su descubrimiento se utilizaron para tratar infecciones bacterianas. Sin embargo, el uso excesivo e inadecuado de los antibióticos ha ocasionado que bacterias, que causan problemas en salud humana, animal y ambiental, sean resistentes a múltiples antibióticos.
La resistencia a los antibióticos ha sido reconocida como una de las principales amenazas para la salud pública, según la Organización Mundial de la Salud (OMS). En este contexto, se destaca la preocupante ineficacia de antibióticos clave, como los carbapenémicos, en más del 50% de las infecciones causadas por Klebsiella pneumoniae.

Además, la falta generalizada de eficacia de las fluoroquinolonas en infecciones por Escherichia coli y la ausencia de antibióticos efectivos para tratar infecciones por Staphylococcus aureus, que aumenta la probabilidad de mortalidad hasta un 64%, subrayan la urgencia de abordar este problema global. La OMS destaca la importancia de concientizar sobre esta amenaza y promover prácticas responsables para preservar la eficacia de los antibióticos y garantizar la salud de las futuras generaciones.

Sumado a lo anterior, el desarrollo de nuevos antibióticos no va a la velocidad que la problemática demanda. Según el informe del 2019 de la OMS, se estima que cada año 700.000 personas en el mundo mueren a causa de infecciones por bacterias multirresistentes.
De no tener una solución para controlar estas bacterias se estima que en el 2050 morirán más personas por infecciones bacterianas que por cáncer y la diabetes. Dada la problemática de resistencia bacteriana a los antibióticos, es imprescindible la búsqueda de alternativas al uso de antibióticos para controlar poblaciones bacterianas. bacterianas. Una de las alternativas viables es el uso de bacteriófagos.
Encuentra aquí más información
Antimicrobianos en producción animal
Antimicrobianos en producción animal
Colombia en la resistencia a los antimicrobianos
Colombia en la resistencia a los antimicrobianos
Vigilancia de la resistencia a los antimicrobianos
Vigilancia de la resistencia a los antimicrobianos
Informe OMS
Informe OMS
Vigilancia de la resistencia a los antimicrobianos
Vigilancia de la resistencia a los antimicrobianos
¿Cómo funcionan los fagos?
Los bacteriófagos son parásitos obligados de
bacterias, son virus que únicamente pueden infectar bacterias. Son las entidades biológicas mas abundantes del planeta tierra y se pueden encontrar en cualquier ambiente, incluyendo, aguas y alimentos de consumo humano.
Para que un fago infecte una bacteria debe: reconocer una parte específica de la célula bacteriana; ingresar sus genes dentro de la bacteria; replicarse al interior de su hospedero; y finalmente, explota la bacteria desde adentro.

Cada vez que un fago infecta una célula bacteriana se replica y salen decenas o cientos de fagos nuevos capaces de infectar otras bacterias. Cuando la población bacteriana disminuye por acción de los fagos, con el tiempo también disminuye la población de los fagos.

Los fagos por ser altamente específicos cuando son seleccionados con precisión, pueden ser usados biotecnológicamente para prevenir y controlar poblaciones bacterianas (incluyendo aquellas resistentes a los antibióticos), permitiendo hacer un control dirigido a las bacterias problema, sin afectar otras bacterias benéficas. Por esta razón los fagos son el nuevo futuro en el control de bacterias problemáticas.



El uso de fagos en la industria agropecuaria tiene varios beneficios
Ayuda a reducir el uso de antibióticos
Disminuye la resistencia bacteriana a los antimicrobianos
Contribuye a mejorar los parámetros productivos
No tiene efectos negativos en la salud de los animales ni el medio ambiente
El consumidor final puede disfrutar de productos agropecuarios más limpios e inocuos
Control eficaz bacteriano
Los bacteriófagos son seguros para humanos, animales y plantas
Artículos científicos

Fagoterapia, alternativa para el
control de las infecciones bacterianas.
Perspectivas en Colombia
https://revistas.javeriana.edu.co/

Phages in Anaerobic Systems
https://www.mdpi.com/

The gastrointestinal microbiome and
its association with the control of
pathogens in broiler chicken
production: A review
https://www.sciencedirect.com

Current Clinical Landscape and Global
Potential of Bacteriophage Therapy
https://www.mdpi.com/

Natural Killers: Opportunities and
Challenges for the Use of
Bacteriophages in Microbial Food
Safety from the One Health
Perspective
https://www.mdpi.com/

PODCAST
Capítulo 6. ¡Los microorganismos
importan! Bacteriófagos: heroes
incomprendidos
https://www.youtube.com/@obviomicro
bio5630
Derechos reservados Sciphage® 2024